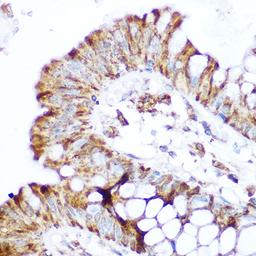
Immunohistochemistry - NOD2 Rabbit pAb (A15992)

Product & ReviewsAntibodies
NOD2 Rabbit pAb
Product Details
- Cat. No.
- A15992
- Type
- Primary Antibody
- Clonality
- Polyclonal
- Host
- Rabbit

The supplier does not provide quotations for this antibody through SelectScience. You can search for similar antibodies in our Antibody Directory.
Description
This gene is a member of the Nod1/Apaf-1 family and encodes a protein with two caspase recruitment (CARD) domains and six leucine-rich repeats (LRRs). The protein is primarily expressed in the peripheral blood leukocytes. It plays a role in the immune response to intracellular bacterial lipopolysaccharides (LPS) by recognizing the muramyl dipeptide (MDP) derived from them and activating the NFKB protein. Mutations in this gene have been associated with Crohn disease and Blau syndrome. Alternatively spliced transcript variants encoding distinct isoforms have been found for this gene.
Biological Information
- Clonality: Polyclonal
- Host: Rabbit
- Reactivity: Human, Mouse, Rat